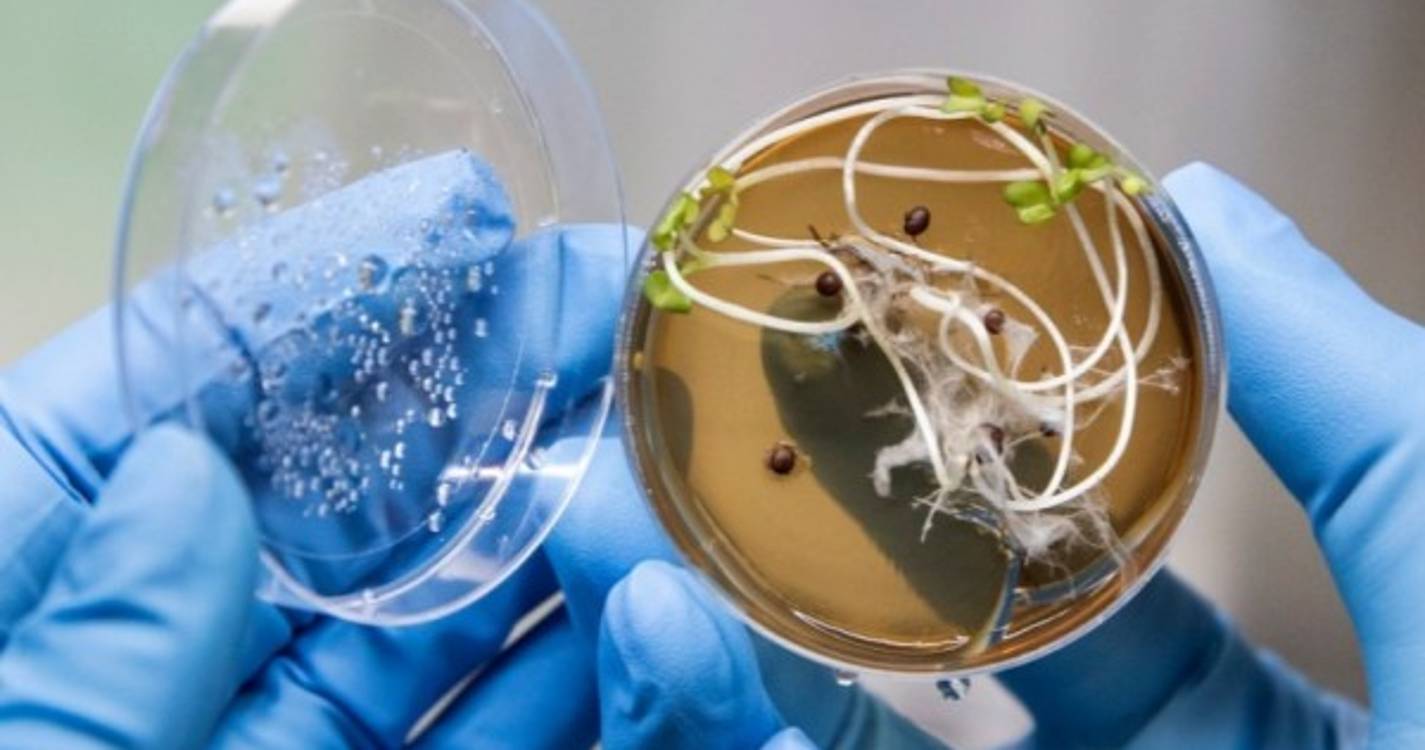
Investigadores do Porto desenvolvem vacina comestível contra a covid-19

Investigadores do Porto desenvolvem vacina comestível contra a covid-19
As vacinas são sinónimo de agulhas, contudo, uma equipa de investigadores do Instituto Politécnico do Porto (IPP) decidiu quebrar a regra e produzir uma contra a covid-19 comestível, em formato de iogurte e sumo de frutos.
Esta ideia, que está a ser maturada desde o aparecimento da pandemia de covid-19, começou a ganhar forma há cerca de seis meses e, desde então, muito já foi feito. Neste momento, estão a decorrer os ensaios `in vitro´ e, brevemente, começam aqueles feitos em animais, contou hoje à Lusa um dos responsáveis pelo Laboratório de Biotecnologia Médica e Industrial - LaBMI do IPP, Rúben Fernandes.
Os ensaios vão ser feitos em ratos, peixes e numa espécie de minhoca muito pequena, salientou.
Falando num projeto "completamente inovador em Portugal", o biólogo explicou que esta vacina, que finalizada poderá ser ingerida em iogurte ou sumo de frutas, tem como particularidade ter por base plantas de frutos e probióticos geneticamente modificados, referiu.
Numa sala pequena, onde predominam máquinas, tubos de ensaio e microscópios, pode ver-se, num espaço reservado e só possível de ser manipulado pelos investigadores devidamente equipados, pequenos tubos com ainda mais pequenas plantas no seu interior e discos de vidro com os probióticos.
"As plantas já estão geneticamente modificadas, assim como os probióticos", esclareceu Rúben Fernandes.
Realçando que a ideia desta vacina é que ela chegue facilmente ao utilizador final, o investigador apontou as diferenças entre as atuais e esta: as atuais estimulam a neutralização do vírus e esta estimula a imunidade.
"Portanto, ambos são produtos preventivos, mas neste caso a vacina, vou dizer convencional, neutraliza uma infeção e as vacinas comestíveis têm a propriedade de poderem potenciar as outras vacinas comuns", explicou.
As vacinas vão poder conjugar os probióticos ou plantas geneticamente modificadas ou usar apenas um deles, frisou.
O biólogo adiantou que usando apenas probióticos esta vacina poderá ser uma realidade entre "seis meses a um ano" porque são bactérias que podem ser rapidamente transformadas.
Já utilizando os frutos, a sua concretização "será bastante mais longa" porque as plantas têm de crescer e dar frutos para que possam ser utilizados na indústria e transformados em sumo, elucidou.
Ressalvando que a vacina está a ser financiada exclusivamente com fundos próprios, Rúben Fernandes observou que vão, numa fase final, ter de se unir a parceiros industriais da área alimentar para a vacina chegar ao consumidor final e ganhar escala.
"Vai ser a indústria que vai decidir que tipo de produto é que vai querer, nós vamos é poder oferecer-lhes várias opções", sustentou.
Apesar de estar a ser direcionada para a covid-19, Rúben Fernandes acredita que a mesma poderá vir a ter interesse para tratar outros tipos de doenças infeciosas.
Sobre a possibilidade de numa eventual nova vaga da pandemia já existir uma vacina comestível, Rúben Fernandes afirmou que "dificilmente".
Lusa